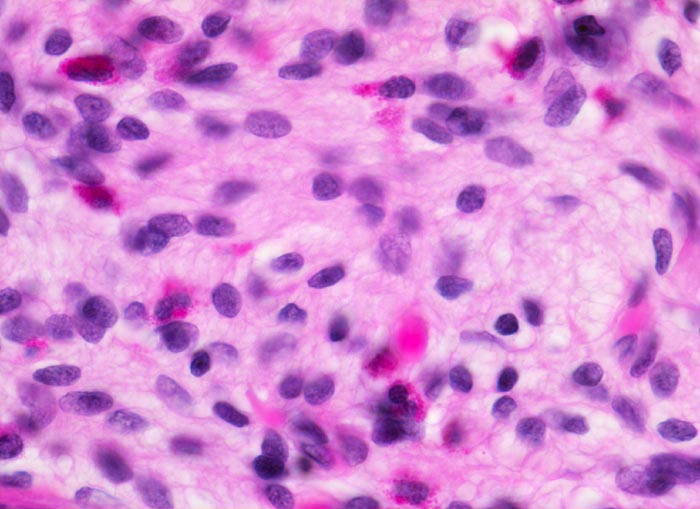

PathoPic – image database / PathoPic ID 3399 - neurogene Appendikopathie Mukosaform
de
Diagnose
neurogene Appendikopathie Mukosaform
Diagnose Gruppe
organspezifische Erkrankung
Topographie
Appendix vermiformis
Topographie Gruppe
Darm, Anus
Beschreibung
Schwann Zell Proliferate durchmischt mit eosinophilen Granulozyten in der Lamina propria.
Klinik
Gelegenheitsappendektomie bei Harnblasenresektion wegen Urothelkarzinom.
Kommentar
Die neurogene Appendikopathie existiert in einer intramucosalen Form, als zentrales Neurom in einer narbig obliterierten Appendixspitze oder als neuromuskuläre Proliferation in der Submucosa.
Bilder Typ
Histologie
Vergrösserung
630
Alter
60
Geschlecht
männlich
Datum
Ersteintrag: 17.12.2001
Update: 29.10.2009